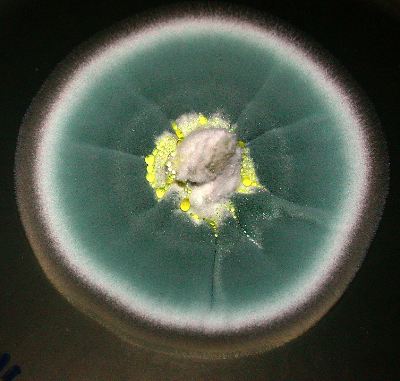
kaskus-image

- Beranda
- Sains & Teknologi
.: 20 Fakta Unik Simbiosis Jamur :.
...
TS
samanosuke20
.: 20 Fakta Unik Simbiosis Jamur :.



HT #6


Jamur atau sering disebut juga sebagai cendawan adalah tumbuhan yang tidak mempunyai klorofil sehingga bersifat heterotrof yaitu konsumer yang membutuhkan dan bergantung pada substrat yang menyediakan karbohidrat, protein, vitamin, dan senyawa kimia lainnya layaknya hewan dan bakteri. Kemudian, tubuh jamur terdiri dari benang-benang yang disebut hifa yang membentuk anyaman bercabang-cabang yang disebut miselium. Jamur menyerap zat organik dari lingkungan melalui hifa dan dengan miseliumnya memperoleh makanannya, lalu, menyimpannya dalam bentuk glikogen. Dalam kesepakatan terakhir, Jamur merupakan kerajaan tersendiri seperti animalia, plantae dan protista (dalam satu domain Eukaryote) dengan memiliki 7 filum, yaitu Microsporidia, Chytridiomycota, Blastocladiomycota, Neocallimastigomycota, Glomeromycota, Ascomycota, dan Basidiomycota. Sementara itu simbiosis merupakan hubungan singkat atau pendek, namun selalunya hubungan dengan jangka panjang antara dua atau lebih organisme, antara lain hubungan yang saling menguntungkan (Mutualisme), yang menguntungkan salah satu pihak sementara yang lain tidak terlalu dirugikan (Komensalime), yang merugikan salah satunya secara langsung (Parasitisme), yang menghambat salah satunya secara tidak langsung (Amensalisme) dan yang merugikan keduanya bahkan sampai kematian (Synnecrosis). Keanekaragaman yang luar biasa pada jamur lengkap dengan keunikannya membuat kita bertanya, bagaimanakah bisa ada perbedaan yang kontras antara satu jamur dengan jamur lainnya, mengapa bisa terjadi? sungguh jawaban kebetulan atau secara otomatis adalah jawaban yang bisa diterima namun memiliki kemungkinan yang sangat sangat sangat kecil alias mustahil. Lantas kenapa kita tidak menerima kemungkinan lain bahwa ada yang mengatur disebaliknya, yang menunjukkan kebesarannya dan keagungannya, Allah ta'ala.
1. Buat yang udah main game the last of us pasti merasa tidal percaya bahwa ada jamur yang bisa menjadikan makhluk hidup sebagai inangnya, namun pada kehidupan nyata hal itu terjadi. "Ophiocordyceps unilateralis" (read: Carpenter Ant Fungus) adalah dari filum Ascomycota serta genus yang biasa menjadikan makhluk hidup sebagai inangnya, dalam hal ini spesies Camponotus leonardi(read: Zombie Ant). Jamur ini menginfeksi kemudian memanipulasi tingkah laku semut inangnya bahkan memanfaatkan mandiblenya untuk kepentingan pertumbuhan jamur tersebut, terutama dari sisi temperatur dan kelembapan, hingga semut tersebut mati [link]. Jamur ini memanfaatkan tangkai yang ramping ke bagian dormal leher semut menyerang hemocoel, mengontrol otaknya sehingga semut hanya menunggu kematiannya, sementara jamur berkembang menjadi Hypha menyebar ke seluruh tubuh inangnya. Proses yang dikenal dengan 'death grip/pegangan kematian' belum benar2 dipahami oleh para ilmuwan, hanya saja jamur tersebut mampu melanjutkan hidupnya dengan berpindah ke inang yang lainnya sekaligus menghancurkan satu koloni. Menurut penelitian terbaru, diketahui jamur ini memproduksi Naphthoquinone yang terdiri dari:
- Erythrostominone,
- Deoxyerythrostominone,
- 4-O-methyl erythrostominone,
- Epierythrostominol,
- Deoxyerythrostominol, dan
- 3,5,8-trihydroxy-6-methoxy-2-(5-oxohexa-1,3-dienyl)-1,4-naphthoquinone,
yang mampu menjadi obat untuk kemoterapi, malaria, tumor, dll.
Lingkar hidup jamur ini adalah, infeksi (melalui penyebaran mikrospora) --> death grip (proses aneksasi jamur terhadap kontrol semut) --> Pertumbuhan Hypa (semut mencari tempat yang sesuai) --> killing zone (jamur mengeluarkan spora melalui stroma menciptakan area seluas 300 cm2)
Spoiler for ..:
Code:
http://news.psu.edu/story/277383/2013/05/21/research/getting-bottom-zombie-ant-phenomenon
http://www.livescience.com/5631-zombie-ants-controlled-fungus.html
Sementara itu, saudaranya "Ophiocordyceps sinensis" (read: Caterpillar Fungus), menginfeksi Hepialus humuli (read: Ghost Moth) dengan proses yang hampir serupa, berkecambah dalam larvanya, membunuh ngengat ini dan menjadikannya mumi [link]. Sementara itu, jamur ini sudah lazim dimanfaatkan oleh manusia, seperti untuk obat penguat layaknya viagra, mengobati penyakit ginjal, paru-paru, dll.
Spoiler for ..:
Code:
https://microbewiki.kenyon.edu/index.php/Ophiocordyceps_sinensis
2. Pada awalnya, semua peneliti bersepakat bahwa organisme hidup terbesar di dunia adalah Balaenoptera musculus(read: Blue Whale), yang memiliki ukuran panjang 30 meter dan berat yang mencapai 190 ton. Akan tetapi, Armillaria solidipes (read: Oregon Monster Mushroom) dari filum Basidiomycota adalah organisme terbesar sebenarnya, yang telah hidup selama hampir 2.400 tahun dengan cakupan wilayah mencapai 8.4 km2 atau panjang 5.6 km, mengingatkan kita akan film Avatar dimana pohon raksasa Vitraya Ramunong atau tree of soul menghujam ke dalam Planet Pandora tepatnya di gunung Hallelujah. Maka, jamur ini juga melakukan hal yang serupa dan nyaris sama di hutan nasional Malheur, Oregon, Amerika Serikat dengan bantuan akar miselium yaitu rhizomorphs, membunuh secara perlahan pohon2 yang tumbuh di sekitarnya. Sementara itu, di pegunungan Adams daerah Washington, ditemukan juga jenis jamur ini yang hampir sama besarnya.
Spoiler for ..:
Code:
http://www.independent.co.uk/news/science/oregons-monster-mushroom-is-worlds-biggest-living-thing-710278.html
http://www.scientificamerican.com/article/strange-but-true-largest-organism-is-fungus/
Kalau bicara maka jamur dengan badan (spocarp) yaitu multisel yang membentuk spora seperti basidium dan ascus maka "Phellinus ellipsoideus" (read: Polypore fungus) dari filum Basidiomycota adalah yang terbesar dengan ukuran volume yaitu 525,000 cm3, panjang mencapai 1,085 cm, lebar 82-88 cm dan ketebalan 4.6-5.5 cm serta berat mencapai 500 kg, yang ditemukan di Provinsi Fujian, China (2011), sebelumnya memiliki nama Fomitiporia ellipsoidea. Sementara sebelumnya "Rigidoporus ulmarius" (read: Elm Fungus) yang terbesar dengan ukuran diameter 133 cm dan lingkar 425 cm yang ditemukan di Kew Garden, Inggris (2003).
Spoiler for ..:
Code:
http://www.bbc.co.uk/nature/14294283
http://eol.org/pages/194682/details
3. Jamur yang sangat indah dan menakjubkan, yaitu "Panellus stipticus" (read: Bitter Oyster) dari filum Basidiomycota dengan ukuran 32 mm yang mengandung pigmen luciferin melalui enzim luciferases sehingga mampu melakukan Bioluminescence sehingga menjadikannya dapat menghasilkan cahaya di tengah kegelapan seperti pada Lampyris noctiluca(read: Glueworm). Sementara itu, keunikan lainnya dari Panellus stipticus adalah mengandung laccase, enzim yang mampu menghancurkan lignin pada beberapa jenis kayu, pemanfaatannya dalam proses bioremediasi terhadap kontaminasi polutan organik ataupun industri daur ulang yang banyak mengandung toksik polyphenols.

Spoiler for ..:
Code:
http://microbewiki.kenyon.edu/index.php/Panellus_stypticus
Ada sekitar 70 fungi lainnya yang mampu melakukan Bioluminescence antara lain, Armillaria gallica(read: Crystal Falls fungus) yang mampu menghasilkan arnamiol yang termasuk sesquiterpenoid aryl ester yang berguna pada proses Prenylation (pengikatan protein), Mycena haematopus (read: bleeding fairy helmet) yang mempunyai pigmen haematopodin B merupakan komponen penting dalam penelitian obat anti-tumor, anti-bakteri dan juga anti-jamur sekaligus pada genus ini yang paling banyak memiliki jumlah jamur bercahaya, Omphalotus olearius (read: Jack-o'-lantern Mushroom) yang beracun karena mengandung illudin yang dapat membuat muntah2, diare dan kram. Ada juga Neonothopanus gardneri (read: George Gardner Fungus) yang dikabarkan paling terang diantara semua jamur bercahaya serta banyak fungi lainnya.
Spoiler for ..:
Code:
http://www.bbc.co.uk/nature/21011428
4. Sementara itu, untuk jamur paling terkecil adalah Saccharomyces cerevisiae(read: Baker's yeast) dari filum Ascomycota yang memiliki diameter 5–10 µm, layaknya bakteri Escherichia coli, jamur ini digunakan pada proses fermentasi anggur, pembakaran kue dan pembuatan bir. Ragi ini memiliki tubuh Berkeley yang memliki fungsi CTV (cytoplasm to vacuole targeting) yang juga punya kemiripan pada autophagosomes pada proses autophagy (proses degradasi sel yang tidak berguna), sehingga sel ragi dijadikan penelitian dalam hal awet muda serta dalam penelitian urutan genomen, meiosis, rekombinasi dan perbaikan DNA.
Spoiler for ..:
Code:
http://www.epa.gov/biotech_rule/pubs/fra/fra002.htm
http://users.rcn.com/jkimball.ma.ultranet/BiologyPages/Y/Yeast.html
5. Calvatia gigantea(read: Giant puffball) dari filum Basidiomycota memiliki diameter mencapai 70-150 cm dengan berat 20 kg yang setiap 10 inchi-nya mengandung sekitar 7 trilyun spora atau secara kasar mengandung 5 juta trilyun (5 x 1018) spora yang terikat kuat oleh capillitium dalam satu bola bundar.
10 inchi = 25,4 cm
berarti dalam 1 cm maka;
7/2.54 = 2.75 (Trilyun)
volume bola = 4/3 (phi) r^3
= 4/3 x 22/7 x (75 x 75 x 75)
= 88/21 x 421.875
= 1.767.857,14
maka 1.767.857,14 x 2,75 (trilyun)
= 4.861.607,14 (trilyun)
Sementara itu, bagian luarnya adalah gleba berwarna putih dan dapat dimakan, namun ketika warnanya berubah menjadi kuning atau cokelat saat tua maka akan menjadi racun. Dikabarkan rasanya mirip dengan Tofu ataupun keju cair. Keunikan yang lain adalah, apabila seluruh spora dalam tubuhnya tersebut tumbuh berkembang sebanyak 2 generasi saja dari jamur bola ini menjadi masing2 satu jamur bola dengan ukuran diameter 300 cm saja (20 kg), maka berat total keseluruhannya 83 milyar x berat bumi (sekitar 6 x 1024), bayangkan ada planet khusus sendiri dengan isi semuanya spora?
20 x 5 x 1018 x 5 x 1018
= 500 x 1036
maka, (500 x 1036) : 6 x 1024
= 83 x 1012
Keunikan lainnya, bisa jadi dengan badan (spocarp) yang sempurna tanpa inang, sebagai spesimen tunggal maka jamur ini adalah yang terbesar di antara semua jamur yang ada.
Spoiler for ..:
Code:
http://blog.mycology.cornell.edu/2006/10/26/giant-puffballs-calvatia-gigantea/
6. Jamur beracun Gyromitra esculenta(read: False Morels) dari filum Ascomycota adalah jamur beracun yang mengandung Gyromitrin, yang mampu menghasilkan toksik monomethylhydrazine (MMH), yang dapat mengakibatkan delirium, merusak sistem saraf pusat dan ginjal, koma kemudian mati setelah 4-7 hari. Efek yang merusak ini membuat racunnya menjadi sangat mematikan meskipun memiliki LD50 yang tidak terlalu besar yaitu 10–30 mg/kg untuk anak and 20–50 mg/kg untuk orang dewasa.
Spoiler for ..:
Code:
http://botit.botany.wisc.edu/toms_fungi/may2002.html
Sementara itu, famili cendawan yang paling banyak mengandung racun adalah Amanita muscaria(read: Fly Agaric) yang mengandung Muscimol dan Asam Ibotenik yang dapat menghasilkan racun CNS, yang dapat menyebabkan berbagai efek psikoaktif yang tidak bisa diprediksi, antara lain hilang keseimbangan, euforia, distorsi visual, perubahan mood secara mendadak, ataxia, agitasi, krisis cholinergic, relaksasi, dll. Sekitar 6 mg muscimol atau 30-60 mg sudah sangat berbahaya bagi orang dewasa, dan jamur inilah yang selalu menemani kita ketika bermain Mario Bross. Sementara jamur lainnya yaitu Tricholoma equestre (read: Man on horseback) mengandung asam cycloprop-2-ene carboxylic yang menyebabkan rhabdomyolysis dimana otot2 pemakannya akan merasakan kesakitan yang parah serta urin yang berubah menjadi cokelat, dan masih banyak jamur beracun lainnya yang mematikan namun mengandung keunikan.
Spoiler for ..:
Code:
http://hubpages.com/hub/List-of-Poisonous-Mushrooms-Poison-Mushrooms-Pictures
7. Selama lebih dari ratusan tahun telah menyebabkan kematian tanpa ada seorangpun yang menyadari sebabnya. Claviceps purpurea(read: Ergot Kernel) dari filum Ascomycota menginfeksi butir gandum dan beberapa sereal. Salah satu komponen berbahayanya adalah alkaloid ergine (d-lysergic acid amide), yang lebih dikenal sebagai LSD yang lebih kuat 4000 kai dari mescaline, yang menyebabkan ergotoxicosis (Saint Anthony's Fire) atau lebih dikenal sebagai terkena sihir/kutukan. Dikabarkan, bahwa efek dari jamur ini menjadi penyebab terjadinya beberapa peristiwa di dunia seperti "Great Fear" (French: la Grande Peur) pada 17 Juli–3 Ugustus 1789 sebagai awal Revolusi Perancis, kemudian "Salem witch trials" di Massachusetts antara Februari 1692 dan Mei 1693 yang mengakibatkan dieksekusinya 20 orang, lalu ritual kesuburan pada saat festival Eleusinian kepada dewa Demeter dan Persephone pada tahun 1500 SM. Begitu juga ritual yang dilakukan oleh Anglo-Saxon yang didokumentasikan dalam puisi Beowulf and Grendel, serta insiden Pont-Saint-Esprit dimana lebih dari 250 orang mengalami halusinasi yang mengakibatkan 50 orang mengalami gangguan jiwa dan 4 orang tewas.
Spoiler for ..:
Code:
http://www.entheology.org/edoto/anmviewer.asp?a=37
8. Siapa sangka kalau ternyata Hydnellum pecki(read: Devil's Tooth) dari filum Basidiomycota adalah yang melakukan simbiosis mutualisme dengan inangnya terutamanya pohon coniferous (divisi Pinophyta) seperti tumbuhan pinus dimana terjadi pertukaran mineral dan asam amino dari dalam tanah dengan hadiah carbon fiksasi dari inangnya (proses konversi karbondioksida dalam fotosintesis atau kemosintesis). Uniknya badan jamur ini dapat mengeluarkan sejenis cairan kental seperti darah karena mengandung anticoagulant seperti heparin.
Spoiler for ..:
Code:
https://bioweb.uwlax.edu/bio203/f2012/deflorin_patr/spooky_story.htm
9. Xanthoria elegans(read: Elegant Sunburst Lichen) yang dari filum Ascomycota ini, termasuk memberikan kontribusi terutamanya dalam bidang arkeologi, palaeontologi dan geomorfologi dalam metode lichenometri untuk mengukur umur bebatuan yang tak terlindungi dengan batasan umur dari 1000-10.000 tahun dengan tingkat eror 10%. Ada 5 metode yang dapat digunakan yaitu, Largest lichen (LL), Largest five lichens (5LL), Fixed-area largest lichen (FALL), Size-frequency approach (SF) dan Lichen cover approach (LC). Sementara itu ditemukan juga anthraquinone dan carotenoids yang berguna pada fotosintesis dan fotooxidasi.
Spoiler for ..:
Code:
http://www.inaturalist.org/taxa/elegant_sunburst_lichen
Diubah oleh samanosuke20 20-06-2014 18:29
0
36.3K
253
Komentar yang asik ya
Mari bergabung, dapatkan informasi dan teman baru!
Sains & Teknologi
15.9KThread•13.6KAnggota
Tampilkan semua post
TS
samanosuke20
#1
10. Tremella mesenterica (read: Witches' Butter) dari filum Basidiomycota yang merupakan parasit dari jamur juga dari genus Peniophora yang biasanya hidup di batang2 pohon yang telah mati, dimana ukurannya diameternya dapat mencapai 7.5 cm. Meskipun, cendawan ini berguna bagi ilmu kesehatan dimana beberapa paten telah ada terutama berhubungan dengan peningkatan kekebalan tubuh, perlindungan terhadap radiasi, efek anti alergi, hypocholesterolemic serta pencegahan kanker karena mengandung polysaccharides.
11. Manusia juga rentan terhadap infeksi jamur, secara umum ada 4 jenis medium penularan penyakitnya yaitu mikosis superfisialyang tumbuh berkembang pada permukaan atas kulit dan rambut, mitosis kulit yang melibatkan infeksi pada kaki, kuku dan kurap, mitosis subkutan yang menembus bawah kulit bahkan sampai ke jaringan tulang dan mikosis sistemik yang menginfeksi organ dalam dan menyebar ke seluruh tubuh. Candida parapsilosis (read: Sepsis Disease), dari filum Ascomycota mampu menyebabkan penyakit kronik pada manusia yaitu sindrom respon inflamasi sistemik (SIRS), yang menyerang kekebalan tubuh, salah satu infeksi ringannya adalah Onychomycosis yang menyerang kuku, sekitar 10% populasi manusia terinfeksi jenis jamur ini, selain itu ARDS (acute respiratory distress syndrome ) juga disebabkan jamur ini mengakibatkan gangguan pada saat pertukaran gas di paru2, sehingga persentase hidup mati sekitar 20%-50% [link].
Sementara itu, Candida albicans(read: Diploid fungus) dimana lebih dari 70% kasus Fungemia diakibatkannya, yaitu keberadaan jamur dalam darah yang dapat menyebabkan Neutropenia dan Leukopenia dimana terjadi penurunan yang signifikan terhadap sel darah putih (neutrophils dan leukocytes) sebagai pertahanan terhadap infeksi bakteri dalam darah. Penyakit yang terjadi di kulit juga dapat disebabkan oleh jamur ini seperti keputihan atau gatal pada selangkangan dan lipatan paha. Sementara itu, Cryptococcus gattii (read: Cryptococcosis Disease) dari filum Basidiomycota mampu mengakibatkan pneumonia dan hydrocephalus, terutamanya kepada manusia yang mengalami penurunan kekebalan tubuh seperti penderita AIDS, dan masih banyak jamur mengerikan lainnya yang menyerang dan menginfeksi manusia.
12. Selain menyerang organik yang hidup seperti manusia, binatang dan tumbuhan, jamur juga dapat tumbuh berkembang terhadap produk2 yang menemani kehidupan manusia. Serpula lacrymans(read: Dry Rot) dari filum Basidiomycota yang akan membusukkan kayu yang jarang dipakai dengan menggunakan kalsium dan ion besi yang diekstrak dari batu atau plaster, jamur ini menyukai suhu sekitar 21-22 °C. Uniknya, di Inggris dikabarkan mengalami kerugian mencapai 150 juta pondsterling setiap tahunnya akibat jamur ini terhadap perabot dan aksesori kayunya biasanya di dalam rumah.
Kemudian, Ganoderma lucidum(read: Lingzhi mushroom) yang merupakan salah satu cendawan tertua yang telah digunakan dalam kesehatan, sekitar 2000 tahun pada peradaban China, juga Jepang, Korea, dlsbnya sebagai obat batuk, asma, arthritis dan insomnia. Selain itu, jamur ini juga memiliki efek yang dapat menghancurkan furnitur di luar rumah karena kemampuannya melemahkan lignin dan selulosa. Jamur yang lain adalah Piptporus betulinus (read: Razor Strop) yang ditemukan pada mumi Otzi the Iceman, yang mengandung asam polyporenic sebagai anti-bakteri. Ada 3 jenis perusakan pada kayu, yaitu Brown Rot, Soft Rot dan White Rot, dan jamur ini biasanya menyerang kayu pohon betula (birch) dan mengakibatkan Brown Rot. Sementara itu, Kretzschmaria deusta menyebabkan Soft Rot pada pohon beech (Fagus), oak (Quercus), lime (Tilia), dan maple (Acer) dimana jamur ini membutuhkan nitrogen dalam proses sintesa enzimnya, hal sama juga dilakukan oleh Xylaria polymorpha (read: Dead Man Finger) dengan menyerap polysaccharide pada pohon, atau batang inangnya. Yang terakhir adalah, Pleurotus ostreatus (read: Tree Oyster Mushroom) mengandung benzaldehyde dan lovatatins yang mampu mengurangi kadar kolesterol serta mengakibatkan White Rot, uniknya jamur ini adalah pangan yang digunakan oleh para prajurit pada saat perang dunia pertama.
13. Ini adalah jamur yang paling terkenal, terutamanya di bidang kedokteran karena digunakan untuk menjaga tubuh dari serangan bakteri dalam bentuk produksi obat penicillin/antibiotik dan produksi makanan, yang merupakan keajaiban dalam sejarah umat manusia. Symbiosis antara Jamur dengan Bakteri dalam kasus ini adalah amensalisme dimana jamur merugikan bakteri secara tidak langsung. Penicillium chrysogenum(read: Penicilin) sinilah sumber pembuatan antibiotik β-lactam yang diektrak dari produk makanan yang mengandung garam, serta berbagai penicilin lainnya seperti roquefortine C, meleagrin, chrysogine, xanthocillins, secalonic acids, sorrentanone, sorbicillin dan PR-toxin. Kemudian, Penicillium expansum (read: Patulin) juga dari filum Ascomycota, biasanya ditemui pada apel memiliki mycotoxin . Lalu, Penicillium camemberti (read: Camembert Cheese) pada produksi keju Camembert, Brie, Coulommiers dan Cambozola. Begitu juga Penicillium glaucum (read: Blue Cheese) digunakan pada pembuatan keju antara lain Bleu de Gex, Rochebaron, and some varieties of Bleu d'Auvergne dan Gorgonzola.
14. Rhodotus palmatus(read: Rosy Veincap) dari filum Basidiomycota, yang keunikan karakteristiknya menyebabkan para ilmuwan begitu susah untuk mengklasifikasikannya, tercatat jamur ini sudah berpindah famili beberapa kali, dari Amanitaceae, lalu Entolomataceae, kemudian Tricholomataceae dan terakhir ke Physalacriaceae. Keunikannya terletak pada struktur hypha dan trama, begitu juga produksi chlamydospore pada saat pertumbuhan serta warna spora serta ornamentasinya (modifikasi dinding spora sebagai akibat ketidakaturan permukaan), membuat Rolf Singer (1951) yang menyimpulkan bahwa seakan2 jamur ini mirip dengan famili Amanitaceae, kemudian Robert Kühner dan Henri Romagnesi (1953) berdasarkan basis warna spora maka menempatkannya pada Tricholomataceae namun ketika mempelajari struktur ultra sporanya, Besson (1969) menemukan perbedaan yang mencolok dimana lebih condong kepada Entolomataceae, akan tetapi Singer (1986) melalui teknik urutan ribosomal DNA maka meralat keputusan sebelumnya dan menempatkannya kembali pada Tricholomataceae dan pada 1988, proposal dibuat untuk membagi famili ini menjadi beberapa genus, dan pada 2009, Index Fungorum dan MycoBank memasukkan ke dalam famili Physalacriaceae. Sungguh disayangkan bahwa jamur ini terancam punah, meskipun diketahui bahwa jamur ini termasuk yang dapat dimakan dan anti-mikroba seperti Bacillus subtilis, disebabkan polusi udara dan penggunaan lahan yang berlebihan.
15. Mutinus caninus(read: dog stinkhorn), dari filum Basidiomycota sangatlah unik karena pada rhizomorphs, nampak semacam telur dengan ukuran panjang 2–4 cm dan lebar 1–2 cm, dimana bagian luarnya mengandung peridium sementara bagian dalamnya ada gelatinous. Ketika telur tadi pecah maka akan terlihat seakan2 bagai karung pada bagian dasarnya yang mengandung gleba.
16. Geastrum saccatum(read: Rounded Earthstar ), dari filum Basidiomycota ini sangat unik karena layaknya bunga yang memiliki kelopak yang bisa membuka. Proses membebaskan konten dalamnya dinamakan dehiscence, dimana pada jamur ini tergantung kepada calcium oxalate. Selain itu, ditemukan juga β-glucan–protein juga nitric oxide synthase dan cyclooxygenase yang berguna sebagai anti-inflamasi, anti-oksidan dan cytotoxic.
17. Hericium erinaceus(read: Bearded Tooth Mushroom) juga dari filum Basidiomycota menjadi satu2nya spesies di Amerika bahkan juga dunia, dimana jamur tersebut menumbuhkan rambut yang menggantung pada inangnya dimana panjangnya mencapai 40 cm. Menurut penelitian terkini dengan tikus, didapatkan threitol, D-arabinitol, dan asam palmitic yang terkandung dalam jamur ini berfungsi sebagai anti-oksidan serta dapat menurunkan darah tinggi serta mengatur lipid darah, bahkan telah digunakan pada pengobatan gastric ulcers dan esophageal carcinoma.
18. Morchella conica(read: Black Morel) dari filum Ascomycota adalah sangat menarik dan unik karena biasanya tumbuh dari hutan yang telah mengalami kebakaran hebat, apalagi jamur ini melakukan mutualisme secara mycorrhiza dengan tumbuhan vaskular, dan dapat ditemui pada pohon oak dan popla. Black Morel adalah yang memulai proses pertumbuhan hutan yang telah terbakar tersebut, kemudian dilanjutkan oleh kuning, abu2 dan hijau secara berturut2. Dikabarkan dalam jamur ini ada toksik hydrazine yang juga digunakan sebagai gas pada kantong udara dan roket. Selain spesies ini, ada 2 Black Morel lainnya yaitu, Morchella elata[ (read: Black Morel) dan Morchella angusticeps (read: Black Morel) dengan perbedaan yang sedikit terutama dari ukuran dan kecerahan warna.
19. Cendawan yang menakjubkan dan mengagumkan dengan warna biru cerahnya, Entoloma hochstetteri(read: Ferdinand von Hochstadter fungus) dari filum Basidiomycota memiliki pigmen azulene serta alkaloid dan asam omega 3 fatty, sementara itu Lactarius indigo (read: Blue Milk Mushroom), mampu melakukan ectomycorrhizal dengan akar mycelium terhadap banyak jenis tumbuhan pinus neotropical seperti Pinus Putih/Kuning/Gelap Mexico, Pinus Hartweg's, Pinus Aleppo Pine, Pinus Hitam Eropa, Pinus Maritim dan Pinus Scots. Sedangkan, Mycena interrupta (read: Pixie's Parasol) juga memiliki pigmen yang sama namun dengan sedikit perbedaan dalam kecerahan warna dan salah satu dari genus Mycena yang tidak mampu bioluminescent, meskipun tumbuh di hutan hujan. Jamur dengan pigmen biru ini sangat dibutuhkan terutamanya di Industri kosmetik [link].
20. Clavaria zollingeri(read: Violet Coral) adalah jamur dari filum Basidiomycota yang sangat indah, mengandung lectins yang dapat menyebabkan agglutinasi yaitu proses merekatnya partikel menjadi skala besar, dimana pengembangannya dapat berupa serum. Jamur ini dapat dimakan namun juga bisa memberikan efek laxative pada proses defakasi menyebabkan mencret-mencret atau diare. Sementara itu, Clavulinopsis corallinorosacea (read: Coral Fungi) juga seperti kebanyakan jamur lainnya, bersifat parasit terhadap inangnya, dan memiliki bentuk yang indah layaknya coral (berbeda dengan kebanyakan bentuk tubuh dan struktur jamur).
Kalau ada kesilapan atau kesalahan dalam penyajian fakta, silahkan TS diberitahukan, begitu juga kalau ada info ter-update, karena TS tidaklah seseorang yang sempurna namun penuh dengan kesalahan. Sebisa mungkin TS melampirkan rujukan serta link untuk memudahkan cross-check fakta yang TS sajikan.
Untuk informasi lebih lanjut bisa merujuk ke buku "Introduction to Fungi" [link]atau "Wood and Tree Fungi: Biology, Damage, Protection, and Use" [link]
TAMBAHAN KASKUSER
Spoiler for ..:
Code:
http://www.first-nature.com/fungi/tremella-mesenterica.php
http://mdc.mo.gov/discover-nature/field-guide/witches-butter
11. Manusia juga rentan terhadap infeksi jamur, secara umum ada 4 jenis medium penularan penyakitnya yaitu mikosis superfisialyang tumbuh berkembang pada permukaan atas kulit dan rambut, mitosis kulit yang melibatkan infeksi pada kaki, kuku dan kurap, mitosis subkutan yang menembus bawah kulit bahkan sampai ke jaringan tulang dan mikosis sistemik yang menginfeksi organ dalam dan menyebar ke seluruh tubuh. Candida parapsilosis (read: Sepsis Disease), dari filum Ascomycota mampu menyebabkan penyakit kronik pada manusia yaitu sindrom respon inflamasi sistemik (SIRS), yang menyerang kekebalan tubuh, salah satu infeksi ringannya adalah Onychomycosis yang menyerang kuku, sekitar 10% populasi manusia terinfeksi jenis jamur ini, selain itu ARDS (acute respiratory distress syndrome ) juga disebabkan jamur ini mengakibatkan gangguan pada saat pertukaran gas di paru2, sehingga persentase hidup mati sekitar 20%-50% [link].
Spoiler for ..:
Code:
http://www.livestrong.com/article/241645-what-are-the-treatments-for-candida-parapsilosis/
http://www.life-worldwide.org/fungal-diseases/candida-parapsilosis/
Sementara itu, Candida albicans(read: Diploid fungus) dimana lebih dari 70% kasus Fungemia diakibatkannya, yaitu keberadaan jamur dalam darah yang dapat menyebabkan Neutropenia dan Leukopenia dimana terjadi penurunan yang signifikan terhadap sel darah putih (neutrophils dan leukocytes) sebagai pertahanan terhadap infeksi bakteri dalam darah. Penyakit yang terjadi di kulit juga dapat disebabkan oleh jamur ini seperti keputihan atau gatal pada selangkangan dan lipatan paha. Sementara itu, Cryptococcus gattii (read: Cryptococcosis Disease) dari filum Basidiomycota mampu mengakibatkan pneumonia dan hydrocephalus, terutamanya kepada manusia yang mengalami penurunan kekebalan tubuh seperti penderita AIDS, dan masih banyak jamur mengerikan lainnya yang menyerang dan menginfeksi manusia.
Spoiler for ..:
Code:
http://www.healthcentral.com/encyclopedia/408/312.html
http://www.bccdc.ca/dis-cond/a-z/_c/CryptococcalDisease/overview/
12. Selain menyerang organik yang hidup seperti manusia, binatang dan tumbuhan, jamur juga dapat tumbuh berkembang terhadap produk2 yang menemani kehidupan manusia. Serpula lacrymans(read: Dry Rot) dari filum Basidiomycota yang akan membusukkan kayu yang jarang dipakai dengan menggunakan kalsium dan ion besi yang diekstrak dari batu atau plaster, jamur ini menyukai suhu sekitar 21-22 °C. Uniknya, di Inggris dikabarkan mengalami kerugian mencapai 150 juta pondsterling setiap tahunnya akibat jamur ini terhadap perabot dan aksesori kayunya biasanya di dalam rumah.
Spoiler for ..:
Code:
http://www.inspq.qc.ca/english/mould-compendium/serpula-lacrymans
Kemudian, Ganoderma lucidum(read: Lingzhi mushroom) yang merupakan salah satu cendawan tertua yang telah digunakan dalam kesehatan, sekitar 2000 tahun pada peradaban China, juga Jepang, Korea, dlsbnya sebagai obat batuk, asma, arthritis dan insomnia. Selain itu, jamur ini juga memiliki efek yang dapat menghancurkan furnitur di luar rumah karena kemampuannya melemahkan lignin dan selulosa. Jamur yang lain adalah Piptporus betulinus (read: Razor Strop) yang ditemukan pada mumi Otzi the Iceman, yang mengandung asam polyporenic sebagai anti-bakteri. Ada 3 jenis perusakan pada kayu, yaitu Brown Rot, Soft Rot dan White Rot, dan jamur ini biasanya menyerang kayu pohon betula (birch) dan mengakibatkan Brown Rot. Sementara itu, Kretzschmaria deusta menyebabkan Soft Rot pada pohon beech (Fagus), oak (Quercus), lime (Tilia), dan maple (Acer) dimana jamur ini membutuhkan nitrogen dalam proses sintesa enzimnya, hal sama juga dilakukan oleh Xylaria polymorpha (read: Dead Man Finger) dengan menyerap polysaccharide pada pohon, atau batang inangnya. Yang terakhir adalah, Pleurotus ostreatus (read: Tree Oyster Mushroom) mengandung benzaldehyde dan lovatatins yang mampu mengurangi kadar kolesterol serta mengakibatkan White Rot, uniknya jamur ini adalah pangan yang digunakan oleh para prajurit pada saat perang dunia pertama.
Spoiler for ..:
Code:
http://www.healthline.com/natstandardcontent/reishi-mushroom
http://pyrenomycetes.free.fr/kretzschmaria/html/Kretzschmaria_deusta.htm
http://www.mushroomexpert.com/pleurotus_ostreatus.html
http://www.psu.edu/dept/nkbiology/naturetrail/speciespages/deadmansfingers.htm
http://www.medicalmushrooms.net/piptoporus-betulinus/
13. Ini adalah jamur yang paling terkenal, terutamanya di bidang kedokteran karena digunakan untuk menjaga tubuh dari serangan bakteri dalam bentuk produksi obat penicillin/antibiotik dan produksi makanan, yang merupakan keajaiban dalam sejarah umat manusia. Symbiosis antara Jamur dengan Bakteri dalam kasus ini adalah amensalisme dimana jamur merugikan bakteri secara tidak langsung. Penicillium chrysogenum(read: Penicilin) sinilah sumber pembuatan antibiotik β-lactam yang diektrak dari produk makanan yang mengandung garam, serta berbagai penicilin lainnya seperti roquefortine C, meleagrin, chrysogine, xanthocillins, secalonic acids, sorrentanone, sorbicillin dan PR-toxin. Kemudian, Penicillium expansum (read: Patulin) juga dari filum Ascomycota, biasanya ditemui pada apel memiliki mycotoxin . Lalu, Penicillium camemberti (read: Camembert Cheese) pada produksi keju Camembert, Brie, Coulommiers dan Cambozola. Begitu juga Penicillium glaucum (read: Blue Cheese) digunakan pada pembuatan keju antara lain Bleu de Gex, Rochebaron, and some varieties of Bleu d'Auvergne dan Gorgonzola.
Spoiler for ..:
Code:
http://herbarium.usu.edu/fungi/funfacts/penicillin.htm
http://www.pbs.org/newshour/rundown/the-real-story-behind-the-worlds-first-antibiotic/
14. Rhodotus palmatus(read: Rosy Veincap) dari filum Basidiomycota, yang keunikan karakteristiknya menyebabkan para ilmuwan begitu susah untuk mengklasifikasikannya, tercatat jamur ini sudah berpindah famili beberapa kali, dari Amanitaceae, lalu Entolomataceae, kemudian Tricholomataceae dan terakhir ke Physalacriaceae. Keunikannya terletak pada struktur hypha dan trama, begitu juga produksi chlamydospore pada saat pertumbuhan serta warna spora serta ornamentasinya (modifikasi dinding spora sebagai akibat ketidakaturan permukaan), membuat Rolf Singer (1951) yang menyimpulkan bahwa seakan2 jamur ini mirip dengan famili Amanitaceae, kemudian Robert Kühner dan Henri Romagnesi (1953) berdasarkan basis warna spora maka menempatkannya pada Tricholomataceae namun ketika mempelajari struktur ultra sporanya, Besson (1969) menemukan perbedaan yang mencolok dimana lebih condong kepada Entolomataceae, akan tetapi Singer (1986) melalui teknik urutan ribosomal DNA maka meralat keputusan sebelumnya dan menempatkannya kembali pada Tricholomataceae dan pada 1988, proposal dibuat untuk membagi famili ini menjadi beberapa genus, dan pada 2009, Index Fungorum dan MycoBank memasukkan ke dalam famili Physalacriaceae. Sungguh disayangkan bahwa jamur ini terancam punah, meskipun diketahui bahwa jamur ini termasuk yang dapat dimakan dan anti-mikroba seperti Bacillus subtilis, disebabkan polusi udara dan penggunaan lahan yang berlebihan.
Spoiler for ..:
Code:
http://www.first-nature.com/fungi/rhodotus-palmatus.php
15. Mutinus caninus(read: dog stinkhorn), dari filum Basidiomycota sangatlah unik karena pada rhizomorphs, nampak semacam telur dengan ukuran panjang 2–4 cm dan lebar 1–2 cm, dimana bagian luarnya mengandung peridium sementara bagian dalamnya ada gelatinous. Ketika telur tadi pecah maka akan terlihat seakan2 bagai karung pada bagian dasarnya yang mengandung gleba.
Spoiler for ..:
Code:
http://www.mushroomexpert.com/mutinus_elegans.html
16. Geastrum saccatum(read: Rounded Earthstar ), dari filum Basidiomycota ini sangat unik karena layaknya bunga yang memiliki kelopak yang bisa membuka. Proses membebaskan konten dalamnya dinamakan dehiscence, dimana pada jamur ini tergantung kepada calcium oxalate. Selain itu, ditemukan juga β-glucan–protein juga nitric oxide synthase dan cyclooxygenase yang berguna sebagai anti-inflamasi, anti-oksidan dan cytotoxic.
Spoiler for ..:
Code:
http://www.mushroomexpert.com/geastrum_saccatum.html
http://www.rogersmushrooms.com/gallery/DisplayBlock~bid~5953.asp
17. Hericium erinaceus(read: Bearded Tooth Mushroom) juga dari filum Basidiomycota menjadi satu2nya spesies di Amerika bahkan juga dunia, dimana jamur tersebut menumbuhkan rambut yang menggantung pada inangnya dimana panjangnya mencapai 40 cm. Menurut penelitian terkini dengan tikus, didapatkan threitol, D-arabinitol, dan asam palmitic yang terkandung dalam jamur ini berfungsi sebagai anti-oksidan serta dapat menurunkan darah tinggi serta mengatur lipid darah, bahkan telah digunakan pada pengobatan gastric ulcers dan esophageal carcinoma.
Spoiler for ..:
Code:
http://www.mushroomexpert.com/hericium_erinaceus.html
18. Morchella conica(read: Black Morel) dari filum Ascomycota adalah sangat menarik dan unik karena biasanya tumbuh dari hutan yang telah mengalami kebakaran hebat, apalagi jamur ini melakukan mutualisme secara mycorrhiza dengan tumbuhan vaskular, dan dapat ditemui pada pohon oak dan popla. Black Morel adalah yang memulai proses pertumbuhan hutan yang telah terbakar tersebut, kemudian dilanjutkan oleh kuning, abu2 dan hijau secara berturut2. Dikabarkan dalam jamur ini ada toksik hydrazine yang juga digunakan sebagai gas pada kantong udara dan roket. Selain spesies ini, ada 2 Black Morel lainnya yaitu, Morchella elata[ (read: Black Morel) dan Morchella angusticeps (read: Black Morel) dengan perbedaan yang sedikit terutama dari ukuran dan kecerahan warna.
Spoiler for ..:
Code:
http://www.mushroomexpert.com/morchellaceae.html
19. Cendawan yang menakjubkan dan mengagumkan dengan warna biru cerahnya, Entoloma hochstetteri(read: Ferdinand von Hochstadter fungus) dari filum Basidiomycota memiliki pigmen azulene serta alkaloid dan asam omega 3 fatty, sementara itu Lactarius indigo (read: Blue Milk Mushroom), mampu melakukan ectomycorrhizal dengan akar mycelium terhadap banyak jenis tumbuhan pinus neotropical seperti Pinus Putih/Kuning/Gelap Mexico, Pinus Hartweg's, Pinus Aleppo Pine, Pinus Hitam Eropa, Pinus Maritim dan Pinus Scots. Sedangkan, Mycena interrupta (read: Pixie's Parasol) juga memiliki pigmen yang sama namun dengan sedikit perbedaan dalam kecerahan warna dan salah satu dari genus Mycena yang tidak mampu bioluminescent, meskipun tumbuh di hutan hujan. Jamur dengan pigmen biru ini sangat dibutuhkan terutamanya di Industri kosmetik [link].
Spoiler for ..:
Code:
http://www.wisegeek.com/what-is-azulene.htm
20. Clavaria zollingeri(read: Violet Coral) adalah jamur dari filum Basidiomycota yang sangat indah, mengandung lectins yang dapat menyebabkan agglutinasi yaitu proses merekatnya partikel menjadi skala besar, dimana pengembangannya dapat berupa serum. Jamur ini dapat dimakan namun juga bisa memberikan efek laxative pada proses defakasi menyebabkan mencret-mencret atau diare. Sementara itu, Clavulinopsis corallinorosacea (read: Coral Fungi) juga seperti kebanyakan jamur lainnya, bersifat parasit terhadap inangnya, dan memiliki bentuk yang indah layaknya coral (berbeda dengan kebanyakan bentuk tubuh dan struktur jamur).
Spoiler for ..:
Code:
http://www.mushroomexpert.com/clavaria_zollingeri.html
Kalau ada kesilapan atau kesalahan dalam penyajian fakta, silahkan TS diberitahukan, begitu juga kalau ada info ter-update, karena TS tidaklah seseorang yang sempurna namun penuh dengan kesalahan. Sebisa mungkin TS melampirkan rujukan serta link untuk memudahkan cross-check fakta yang TS sajikan.
Untuk informasi lebih lanjut bisa merujuk ke buku "Introduction to Fungi" [link]atau "Wood and Tree Fungi: Biology, Damage, Protection, and Use" [link]
TAMBAHAN KASKUSER
Quote:
Diubah oleh samanosuke20 16-06-2014 17:31
0